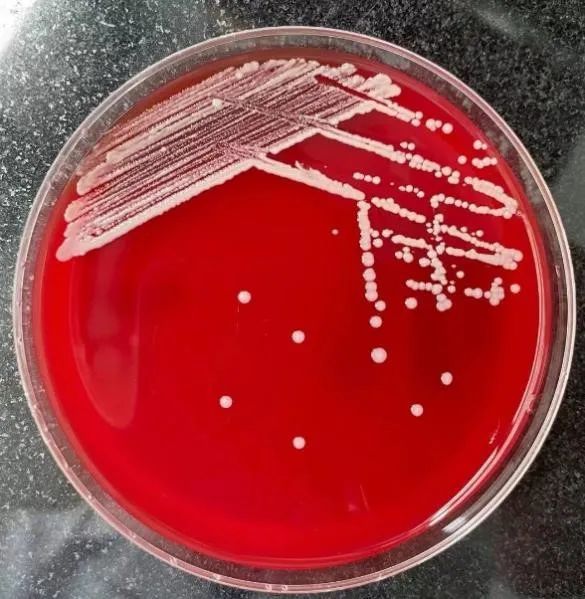

2021-09-24 17:00
作者 张媛媛

京港感染论坛
十年京港,逐梦感染病精准诊疗
患者,男,67岁,慢性肾衰竭,维持性腹膜透析13年余,一直在我院肾内科门诊就诊。4个月前,患者于腹透后出现间断下腹部绞痛,腹透液浑浊,超滤量较前有所下降,来我院肾内科就诊。当时查腹透液常规白细胞7352/ul,多个核89%,考虑腹膜透析相关腹膜炎。后经治疗腹痛好转,腹透液澄清。此次常规就诊患者诉偶有腹部隐痛,腹透液清晰,超滤量较以前无明显变化,规律复查腹透液常规,并送微生物培养、腹透液测序检查。
实验室检查
WBC:6.59*10⁹/L, N%:69.7%, LDH:248U/L, Urea:24.61mmol/L, Cr:1269umol/L, P:1.82mmol/L。腹透液白细胞216/ul,多个核60%。
患者腹透液被注入血培养需氧瓶、厌氧瓶后,放入梅里埃VirtuO全自动血培养仪中培养,需氧瓶在36.7小时后报阳。将报阳培养液在血平板、伊红平板上进行转种,并制备涂片。涂片直接进行革兰染色,镜下可见细菌呈多形性,球形、球杆状、杆状(如图1)。转种的血平板、伊红平板放37℃,5%CO2培养,24小时后平板上生长灰白色细小菌落,无溶血环。48小时后,菌落呈白色中等菌落。72小时后,菌落呈白色大圆菌落,且中央呈皱缩状,凸起,高度卷曲(如图2—图4)。伊红平板无菌落生长。

图1:需氧瓶报阳后直接涂片,革兰氏染色,镜下细菌形态呈多形性。

图2:24h,5%CO2,细小菌落
图3:48h,5%CO2,中等菌落

图4:72h,5%CO2,大圆菌落
将生长3天的菌落边缘和中央进行涂片,边缘菌落整齐,表面光滑,革兰染色多呈球状、球杆状(如图5)。中央菌落凸起、高度卷曲,革兰染色多呈杆状、长杆状(如图6)。

图5:边缘菌落多成球状、球杆状
图6:中央菌落多呈杆状、长杆状
纯菌落用MALDI-TOf MS进行质谱鉴定。质谱鉴定为空气罗氏菌(Rothia aeria),评分为2.122分。同时,提取DNA后送16SrRNA进行测序,结果为Rothia aeria,一致率为98%。肾内科门诊送腹透液测序回报结果为Rothia aeria,与培养结果一致。根据WS/T639-2018,空气罗氏菌药敏参照棒状杆菌属。
治疗经过
4个月前,患者腹透后出现间断下腹部绞痛,腹透液浑浊,考虑腹膜透析相关腹膜炎,给予头孢曲松钠+万古霉素入腹透液治疗,患者腹痛好转,腹透液澄清。3个月前,患者在换出口管后再次出现下腹部绞痛,给予头孢曲松钠+万古霉素入腹透液,同时口服制霉素片+左氧氟沙星治疗,腹疼好转。1个月前,停用左氧氟沙星,给予给予头孢曲松+万古霉素入腹透液,同时口服制霉素片治疗。1周前,改为制霉素片+万古霉素入腹透液治疗。此次常规就诊腹透液培养见空气罗氏菌后,给予头孢曲松钠+万古霉素入腹透液,制霉素+利奈唑胺抗感染治疗,治疗后患者无明显腹痛,腹透液清亮,超滤量维持在1000-1200ml/天,复查腹透液常规未见异常。
1.罗氏菌属中与临床感染相关的有3个:龋齿罗氏菌(R.dentocariosa)、黏滑罗氏菌(R.mucilaginosa)和空气罗氏菌(Rothia aeria)。这些菌是健康口腔中的定植菌,但在一些不健康的口腔中可引起致病。它们还可能会导致血流感染、心内膜炎或其他感染。这些菌引起的感染大多数与使用免疫抑制剂治疗基础疾病有关。
2.在一些研究中,空气罗氏菌可以在十二指肠定植,除了引起常见的口腔易位外,还可以假设肠道易位的可能性。空气罗氏菌还能够感染身体的各个部位,特别是在免疫功能低下的患者中更易感染。该患者长期做维持性腹膜透析,不排除有肠道易位的可能性。另外,该患者除有腹膜透析相关性腹膜炎、慢性肾衰竭、继发性甲状旁腺功能亢进等疾病外,还有2型糖尿病、高血压等基础疾病。腹膜透析时,大量蛋白质从透析液中丢失,可导致低蛋白血症;慢性肾衰竭能导致患者营养不良、肾性贫血;慢性肾衰合并继发性甲状旁腺功能亢进时,可导致患者免疫低下。患者本身患有的糖尿病、高血压等基础性疾病也可导致患者免疫功能低下。这些因素导致患者容易感染空气罗氏菌。
3.该病人在5月14日、7月2日做维持性腹膜透析时,送腹透液常规和微生物培养,见表1:

三次腹透液培养,需氧瓶均检测出空气罗氏菌,空气罗氏菌为需氧兼性厌氧菌,生长缓慢。腹透液培养出空气罗氏菌后,临床给予抗生素抗感染治疗,患者临床症状缓解,腹透液清亮,复查腹透液常规无异常。因腹透液反复检测出空气罗氏菌,且用抗生素抗感染治疗有效,考虑为腹透管处细菌定植可能性大。
4.空气罗氏菌因形态与诺卡菌相似,容易被误认为是诺卡菌属。可对菌落进行弱抗酸染色,空气罗氏菌弱抗酸阴性(-),诺卡菌属弱抗酸(+)。因此,对两者可以采用MALDI-TOF MS和16SrRNA测序进行鉴别。空气罗氏菌很少能引起呼吸道感染,但在与诺卡菌属的鉴别诊断中应予以考虑,特别是易受诺卡菌感染的免疫功能低下的患者中。

5.与此同时,在7月27日痰培养标本中我们分离到一株黏滑罗氏菌。镜下革兰氏染色黏滑罗氏菌为革兰阳性球菌, 多呈四联状排列,也可成双排列(图7),因此黏滑罗氏菌曾为黏滑口腔球菌,微球菌属,微球菌科。现被划归为罗氏菌属,放线菌科。在血琼脂平板上,黏滑罗氏菌呈灰白色中等圆形,干燥菌落。菌落黏性强,多牢固黏附于血琼脂平板上,不易刮取(图8)。菌落及形态与许多近缘菌如微球菌属及奈瑟菌属十分相似,若不加以染色,往往凭经验当作奈瑟菌处理。该菌触酶试验阴性,用MALDI-TOf MS进行质谱鉴定为R.mucilaginosa。黏滑罗氏菌是人类呼吸道的常居菌种,为条件致病菌,可引起免疫力低下患者伤口严重感染和心内膜炎。但需要注意的是因本菌为上呼吸道寄居菌, 呼吸道标本检出本菌应结合临床症状及检出菌量综合考虑其致病性。

图7:显微镜下菌落形态

图8:血平板菌落形态
6.随后几天我们在痰标本里面又发现了几例黏滑罗氏菌,说明黏滑罗氏菌在痰培养中常可见。只是由于其菌落形态与奈瑟氏菌属及其相似,在未进行革兰氏染色的情况下,我们常常把它误认为是奈瑟氏菌属。如在免疫功能低下,菌落多且纯的情况下,它可能会致病,也可能会漏检。在日常工作中,我们如果遇到这种多且纯、干燥、粘平板的细菌还是应该多涂片镜检,确定细菌的种类,以防漏检。
参考文献(上下滑动)
[1] Rothia aeria endocarditis in a patient with a bicuspid aortic valve: case report.brazjinfectdis.2014;1 8(5):561–564
[2] Rothia aeria as a Cause of Sepsis in a Native Joint. JOURNAL OF CLINICAL M ICROBIOLOGY , July 2010, p.2648–2650
[3] Rothia aeria Neck Abscess in A Patient with Chronic Granulomatous Disease: Case Report and Brief Review of the Literature. J Clin Immunol.2012 December ; 32(6): 1400–1403
[4] 临床微生物学手册 第12版 第一卷 原著者:Karen C. Carroll[美]、Michael A. Pfaller[美]主译:王辉、马筱玲、钱渊、李若瑜、曹建平
作者简介

张媛媛
任职于重庆市急救医疗中心检验科微生物组,主管技师,现在在北京大学人民医院检验科微生物组进修。长期从事临床微生物检验工作,研究方向:临床微生物学检验和细菌耐药机制的研究。
END
作者|张媛媛
审校|王占伟



